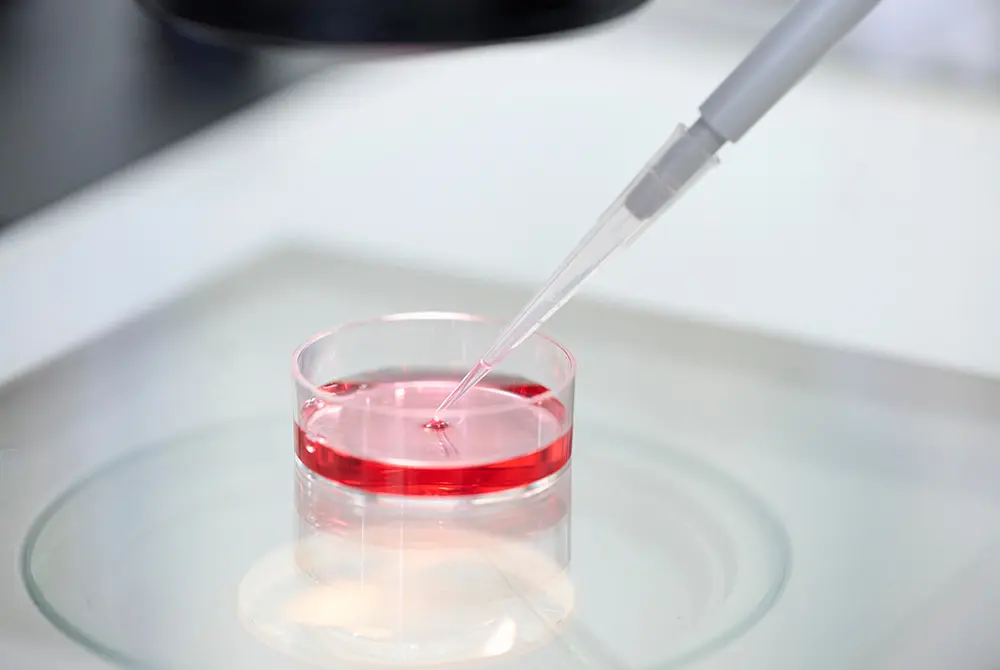
細胞の培養などで衛生管理が保たれていたか？画像はイメージ。（写真／Adobe Stock）

腰椎穿刺により幹細胞を注入した。画像はイメージ。(写真/Adobe Stock)
日本国内で2025年8月に再生医療を受けた外国籍の人物が急変し、亡くなったことが厚生労働省から報告された。
これを受けて国内外の再生医療の事故を報告した論文などをウオッチしていく。
今回は、米国の研究チームが2023年に報告した、医療ツーリズムでメキシコに渡航し、幹細胞治療を受けた後に感染症を発症した事例について確認する。
幹細胞ツーリズムで「脊髄くも膜下腔」に注射

腰椎穿刺。画像はイメージ。(写真/Adobe Stock)
- 2023年の報告→米・コロラド大学の研究チームが、メキシコのクリニックで治療を受けた女性の被害を報告
- 治療内容→2022年10月、メキシコのクリニックで他人由来の臍帯幹細胞を、腰椎穿刺により髄腔へ2回注入
- 体調悪化の経緯→2回目の注入翌日に頭痛と発熱が出現、米国の救急を受診
前回の短期連載では、欧州の幹細胞移植で起きた被害について伝えた。スロベニアからウクライナに幹細胞治療を受けに行き、6カ月が経ってから体調が悪化し、治療を受けた男性が亡くなったという事例だった。この治療は承認を受けていない治療だったが、同じように公的には承認を受けていない幹細胞治療を海外で受ける医療ツーリズムが広がりを見せている。
今回、米国コロラド大学を中心とした研究チームが報告したのは、メキシコのクリニックで幹細胞治療を受けた女性のケースだった。結果として重い感染症を発症した。
報告によれば、治療を受けたのは30代の女性で、自己免疫性疾患の一つである多発性硬化症(MS)を患っている人物だった。この治療のために幹細胞治療に臨んでいた。
※多発性硬化症は、自分自身の免疫の影響で、神経の破壊が進行するなどの異常が起こる病気。腕や脚のしびれなどの症状が現れる。免疫の機能を抑える薬が使われる。
この女性は2022年10月にメキシコのバハカリフォルニア州のクリニックを訪れ、本人以外から採取された臍帯幹細胞(へその緒由来)を、4日の滞在中に腰椎穿刺(ようついせんし)で髄腔(くも膜下腔)へ2回注入された。
※腰椎穿刺は、腰の背骨の辺りから脊髄が通る空間に注射を行うもの。くも膜下腔への注入とは、脊髄の周囲に存在するクモ膜と呼ばれる膜の下部の空間のこと。
ところが、女性は2回目の注入の翌日に米国内の救急を受診し、頭痛や夜間の発熱を訴えた。
当初は腰椎穿刺後の「髄液漏」と判断され治療された。一方で、発熱が持続し、「細菌性髄膜炎」を想定して、抗菌薬を開始した。一般的な感染症と考えられたが、症状は悪化し再入院した。
治療方針が決まるまでに合計8週間
細胞の培養などで衛生管理が保たれていたか?画像はイメージ。(写真/Adobe Stock)
- 感染の特定→髄液検査で「非結核性抗酸菌(M. abscessus)」が検出され、診断確定までに8週間かかった
- 感染経路の可能性→非結核性抗酸菌は土や水に存在し、消毒などの衛生管理が不十分な場合に混入の恐れがある
- 長期的な影響→感染症の影響により、持病の多発性硬化症の免疫抑制治療が難しくなり、神経障害の悪化リスクも示唆された
最終的に、医療機関で髄液の検査により、「非結核性抗酸菌(M. abscessus)」が見つかり、救急を受診してから治療方針が固まるまでに8週間を要する結果になった。
見つかった非結核性抗酸菌は、土や水の中に存在する結核菌の近縁菌の一つで、消毒など衛生的な問題がある場合に混入し得る。今回の感染症は髄液で細菌が増えたもので中枢神経系に感染したことになる。こうした中枢神経系での感染はまれながら、発症すると診断や治療が極めて難しい。
女性は複数の薬を組み合わせた治療により、薬の副作用が出つつも3週間で細菌が陰性になり、症状も改善傾向になった。
ただし、診断と治療までに時間を要した上に、感染症の影響により、持病である多発性硬化症を治療するための免疫抑制療法の開始や継続が難しくなり、神経障害が悪化する可能性も指摘された。
研究チームは「幹細胞ツーリズムは科学的根拠に乏しく、適切な臨床試験を経ていない施術が多い」と警鐘を鳴らした。
少なくとも髄腔内への幹細胞治療は、有効性や安全性が確立していないことを理解する必要があるだろう。








